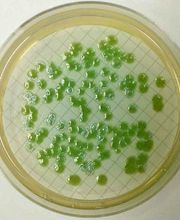
Aquanalyse Laboratoire image 2
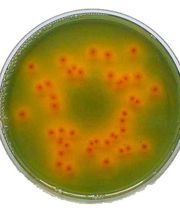
Aquanalyse Laboratoire image 3
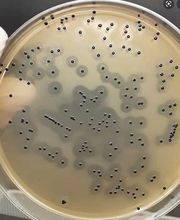
Aquanalyse Laboratoire image 4
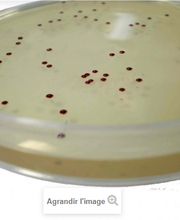
Aquanalyse Laboratoire image 6

Plancy Meca
Outils de précision
3 Route Champfleury, 10380 Plancy l'abbaye+33325373293 (Téléphone)
Notre laboratoire d'analyses d'eaux intervient pour tous les contrôles sanitaires. Nous mettons à votre disposition un service complet, du prélèvement au rapport. Contactez-nous pour toute information supplémentaire.

De Crève Cœur, 10380 Plancy-l'Abbaye
Outils de précision
3 Route Champfleury, 10380 Plancy l'abbaye